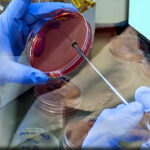

Un ensayo del INTA Reconquista, en Santa Fe, evaluó el uso de imágenes multiespectrales, tomadas con drones, para ajustar la fertilización nitrogenada en girasol, según el estado del cultivo. Del estudio resultó que un menor uso de fertilizantes implica una reducción de los costos y una mejora en la eficiencia sin comprometer los rendimientos.

Un equipo de especialistas del INTA Reconquista, en Santa Fe, puso a prueba una estrategia de fertilización basada en agricultura de precisión. Mediante el uso de drones para relevar el estado del cultivo y algoritmos que procesan esa información, lograron generar mapas de recomendación que permiten ajustar la dosis de nitrógeno en cada sector del lote.
“Logramos reducir de manera significativa la cantidad de nitrógeno aplicado sin perder rendimiento. La clave fue usar información precisa del cultivo para ajustar la fertilización en cada sector del lote, dándole a cada ambiente exactamente lo que necesita”, explicó Gonzalo Scarpín, investigador del INTA Reconquista.
El trabajo se enfocó en reemplazar el esquema tradicional de fertilización uniforme por un manejo sitio-específico, apoyado en herramientas de agricultura de precisión. En lugar de aplicar la misma dosis en todo el lote, la estrategia buscó identificar las diferencias dentro del cultivo y ajustar el aporte de nitrógeno según la necesidad real.

Para generar esa información, el lote fue relevado con un dron equipado con sensores multiespectrales. El equipo captó datos sobre el estado del cultivo a partir de distintos índices vegetativos —NDVI, GNDVI y NDRE— que permiten detectar variaciones de vigor entre sectores.
“Previo a la fertilización realizamos un vuelo con dron que nos permitió obtener mapas muy detallados del cultivo. Esa información es la base para tomar decisiones más precisas”, sostuvo Scarpín.
Los datos generados por el dron fueron procesados mediante un algoritmo que transformó las diferencias observadas en el lote en un mapa de recomendación de fertilización. A partir de ese procesamiento, se definieron dosis específicas de nitrógeno para cada sector.
“El algoritmo traduce los colores del mapa en una recomendación concreta. Así podemos aplicar más nitrógeno donde el cultivo lo necesita y menos donde no hace falta”, detalló Daniela Vitti Scarel —especialista del INTA Reconquista—.

El ensayo comparó este manejo con la fertilización tradicional de dosis fijas y con parcelas sin aplicación de nitrógeno. Los resultados mostraron que, en los tratamientos variables, la cantidad promedio aplicada se redujo de manera marcada: “En muchos casos la dosis total fue menos de la mitad de la que se aplica con un manejo uniforme”, señaló la investigadora.
A pesar de esa reducción, los rendimientos se mantuvieron en niveles competitivos. Esto permitió mejorar la eficiencia en el uso del nitrógeno, es decir, la cantidad de grano obtenida por cada kilo de fertilizante aplicado.
El trabajo confirma el potencial de integrar drones, algoritmos y análisis de datos para transformar la información del cultivo en decisiones de manejo más precisas. Estas herramientas ofrecen una vía concreta para optimizar uno de los insumos más relevantes de la producción agrícola.
Fuente: Inta Informa